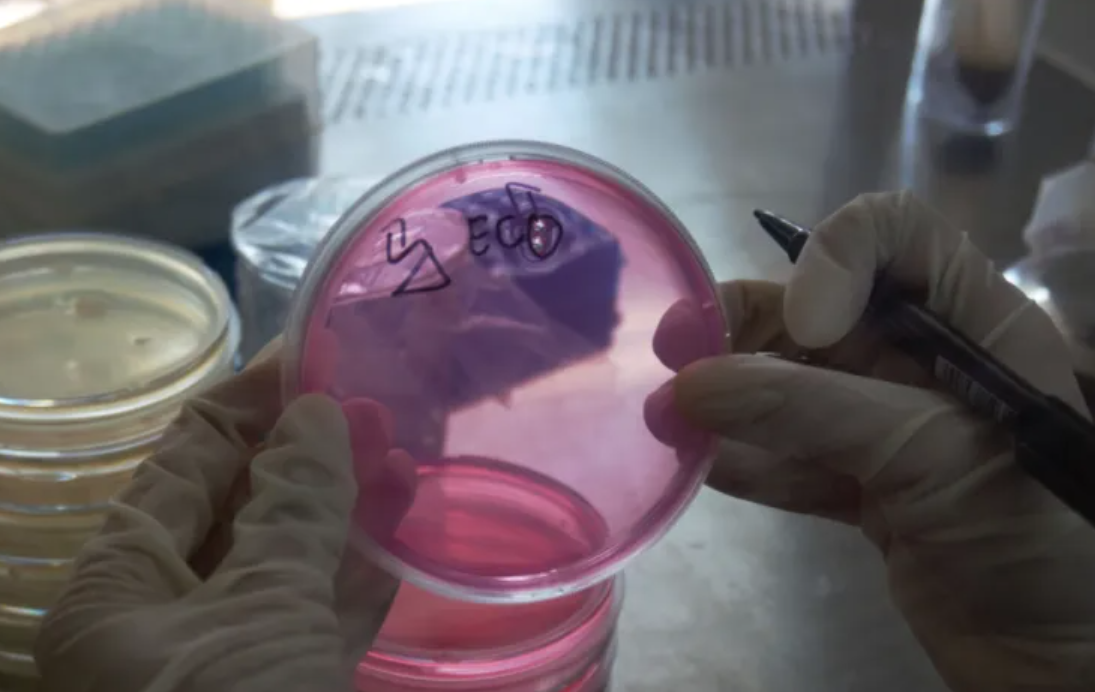

光合作用相关知识经典问答
1.对于高等植物来说,叶片是进行光合作用的主要器官,这些植物的叶片多数是绿色,“多数”如何理解?
植物叶片呈现的颜色是叶片各种色素的综合表现,其中主要的影响因素是绿色的叶绿素和黄色的类胡萝卜素两大类色素之间的比例。高等植物叶片所含的各种色素的数量与植物种类、叶片老嫩、生育期及季节有关。一般来说,正常的叶子的叶绿素和胡萝卜素的比例约为3:1。叶绿素a和叶绿素b的比例也约为3:1,叶黄素和类胡萝卜素的比例约为2:1。由于绿色的叶绿素比黄色的类胡萝卜素多,占优势,所以正常的叶片总是呈绿色。秋天、条件不正常或者叶片衰老时,叶绿素较容易被破坏或降解,数量减少,而类胡萝卜素比较稳定,所以叶片呈现黄色。至于红叶,因秋天降温,体内积累了较多的可溶性糖以适应寒冷,就形成了较多的花青素(红色),叶片就呈红色。枫树的叶片秋季变红,绿肥紫云英在冬天寒潮来临后叶茎变红,都是这个道理。
参考文献:
1.潘瑞炽.植物生理学(4版)[M].北京,高等教育出版社
2.叶绿素是蛋白质吗?
叶绿素有一个类卟啉环结构,中心配位镁离子,该部分组成键网中的电子吸收光;还有一条长的叶绿醇侧链构成的疏水性尾部,能将叶绿素锚定在光合膜上。不同叶绿素的主要区别在于类卟啉环周围的取代基和双键类型不同。
叶绿素不是蛋白质。分离出来的叶绿素分子是不能将它所吸收的光能转化成生命系统可利用的能量形式的,它必须与适当的蛋白质结合在一起并埋在光合膜内才能发挥作用。在植物类囊体膜和光合细菌的膜中,吸光叶绿素与多种蛋白质组成一个大型复合体称作光系统。每个光系统的捕获光能的天线部分有数百个叶绿素分子。
参考文献:
1.潘瑞炽.植物生理学(4版)[M].北京,高等教育出版社
3.光照强度超过一定值,光合速率会下降吗?植物如何应对?
光是光合作用的能源,光能超过光合系统所能利用的数量时,过剩光能可能具有破坏性。多余光能对光合作用产生抑制作用使光合作用的量子效率下降的现象叫作光抑制。当所超出的光能并不多时,光合量子效率下降,但光合作用的最高速率并不受影响,这种降低通常是暂时的,当光强下降到饱和光强以下时可以恢复原来的水平;当多余的光能不能完全被转化为热能耗散掉时就会对光系统造成损伤,这时不仅量子效率降低,光合最高速率也会下降,而且这种光抑制是较长期的,可维持数周甚至数月。
光合生物一般都具有复杂的调节和修复机制。避免遭受光损伤可以从多个水平上进行。第一道防线是以热能的形式来淬灭过多的激发能,从而防止破坏。如果还有剩余,就会形成有毒的光产物,可以通过第二道防线的多个清除系统来消除。如果第二道防线仍然失败,光产物将会破坏光系统Ⅱ(PSⅡ)的D1蛋白,导致光抑制,光合作用速率下降。D1蛋白从PSⅡ反应中心被切离并降解,新合成的D1蛋白会被重新插入到PSⅡ反应中心,形成有功能的单位。
植物还可以通过叶子运动,调节角度去回避强光;叶绿体运动到细胞表面平行于入射光方向排列,以避免过多地吸收光能。这些都是在强光下植物的保护性反应。
参考文献:
1.潘瑞炽.植物生理学(4版)[M].北京,高等教育出版社
4.光合作用一定需要叶绿素分子参与吗?
是的。叶绿素分子有吸收、传递和转化光能的作用。每吸收一个光子必须由几百个叶绿素分子组成的功能单位参与才能完成。光合细菌虽然没有叶绿体和类囊体,但含有类似植物叶绿素a的光合色素—细菌叶绿素,用来捕获光能。
在光合作用中,当类胡萝卜素、叶绿素这些聚光色素吸收光能后,光能经过色素之间的传递到达反应中心。反应中心是将光能转化为化学能的膜蛋白复合体,其中包含参与能量转换的特殊叶绿素a。特殊叶绿素a被光激发成为激发态,迅速交出一个电子,传给原初电子受体,此时特殊叶绿素a被氧化成了带正电荷的氧化态,而原初电子受体被还原成带负电荷的还原态,这样就产生了一个不可逆的电荷分离,发生氧化还原的化学变化。
参考文献:
1.潘瑞炽.植物生理学(4版)[M].北京,高等教育出版社
5.光能利用率,光合作用效率有什么异同?
所谓光能利用率,是指植物光合作用所累积的有机物所含的能量,与同期照射在单位地面上光能量的比。植物的光能利用率约为5%。
光合作用效率是指绿色植物通过光合作用制造的有机物中所含有的能量与光合作用中吸收的光能的比值。农作物的光合作用效率与C02浓度、光照强度、温度、矿质元素等有密切关系;光能利用率与复种指数、合理密植、作物生育期植株株型、C02浓度、光照强度、温度、矿质元素等都有密切关系。因此,提高光合作用效率能够提高光能利用率,提高光能利用率不一定能提高光合作用效率。但二者均影响农作物产量,即提高光能利用率和提高光合作用效率均能提高单位面积上农作物的产量。
参考文献:
1.潘瑞炽.植物生理学(4版)[M].北京,高等教育出版社
6.叶绿素溶液在反射光下呈红色,这种现象称为荧光现象。何为荧光现象呢?
所谓荧光,指一些物质在受到激发光照射时,会产生比原激发光波长更长的可见光,将这种光叫作荧光,这种现象叫作荧光现象。离体叶绿体色素分子吸收光量子后,由最稳定的、能量最低的基态跃迁到不稳定的、能量较高的激发态。由于激发态极不稳定,迅速向低能态转变,在这一过程中,一部分能量以热能的形式耗散,另一部分以光形式消耗,从第一单线态回到基态所发出的光就是叶绿体色素的荧光。由于色素分子吸收的能量中总有一部分能量用于分子内部振动和以热能的形式而消耗,释放出的荧光的波长比原激发光的波长要长,这就是叶绿体色素产生荧光的机理,所以荧光现象是指“反射光下的红色”而非“透射光下的绿色”。
参考文献:
1.潘瑞炽.植物生理学(4版)[M].北京,高等教育出版
7.纸层析法时,若样品较稀怎么办?需要注意什么?
对于较稀的样品,纸层析法时,点一次数量不够,可以连点几次,但每次点后,应待溶剂挥发干后再点第二次,可以用电吹风吹干,但不能吹得过分干燥,否则样品会牢固地吸在滤纸上,造成“拖尾”现象。点样后所形成的原点面积越小越好,一般原点直径以不超过2~3mm为宜。如果溶液过稀,点样时溶剂扩散而起展开作用,容易点成空心圈,层析后会造成畸形斑点。
参考文献:
1.杨昌鹏,张爱华.生物分离技术[M].北京:中国农业出版社
8.植物叶片为什么会出现黄化现象?
一般植物在黑暗中不能合成叶绿素,但能形成胡萝卜素,导致叶子发黄,称为黄化现象。影响叶绿素代谢的因素都可能导致植物叶片黄化。影响植物叶绿素代谢的因素主要有:
(1)光,是影响叶绿素形成的主要条件,因此黑暗中的植物会发生黄化现象。
(2)温度,叶绿素的生物合成是一系列酶促反应,酶的活性受温度影响。叶绿素形成的最低温度约为2℃,最适温度约为30℃,最高温度约为40℃。高温下叶绿素分解大于合成,因而夏天绿叶蔬菜存放不到一天就变黄。
(3)矿质元素,矿质元素对叶绿素形成也有很大的影响。植株缺乏氮、镁、铁、锰、铜、锌等元素时,就不能形成叶绿素,呈现缺绿病。氮和镁都是组成叶绿素的元素。铁、锰、铜、锌等元素,是叶绿素形成过程中某些酶的活化剂,在叶绿素形成过程中起间接作用。
(4)氧,缺氧能引起Mg-原卟啉X或Mg-原卟啉甲酯的积累,影响叶绿素的合成的。
(5)水,缺水不但影响叶绿素生物合成,而且还促使原有叶绿素加速分解,所以干旱时叶片呈黄褐色。
此外,叶绿素的形成还受遗传因素控制,如水稻等。植物体内的叶绿素在代谢过程中一方面合成,一方面分解,在不断地更新。如环境不适宜,叶绿素的形成就受到影响,而分解过程仍然进行,因而茎叶发黄,光合速率下降。
参考文献:
1.潘瑞炽.植物生理学(4版)[M].北京,高等教育出版社
9.生活在干旱地区的景天科植物,如仙人掌、菠萝等,为减少蒸腾作用,白天气孔关闭,不吸收CO2。景天科植物如何固定CO2,并进行光合作用?
夜间,景天科植物气孔开放,大气中CO2自气孔进入细胞质中,被磷酸烯醇式丙酮酸(PEP)羧化酶催化,与PEP结合形成草酰乙酸,再经苹果酸脱氢酶作用还原为苹果酸,贮于液泡中,其浓度可达100mmol/L。尽管白天气孔关闭,但液泡中的苹果酸可运到胞质溶胶,在NADP苹果酸酶作用下氧化脱羧,产生CO2,被释放的CO2参与光合作用的碳循环重新被固定,最终形成淀粉等糖类。所以植物体在晚上的有机酸含量十分高,而糖类含量下降;白天则相反,有机酸下降,而糖分增多。这种有机酸合成日变化的代谢类型,称为景天科酸代谢。
参考文献:
1.潘瑞炽.植物生理学(4版)[M].北京,高等教育出版社
10.光合细菌都释放氧气吗?
能进行光合作用的生物除了绿色植物之外,还有许多原核生物,例如蓝细菌。原核生物进行光合作用时,有的能释放氧,有的则不能释放氧。前者主要指蓝细菌目中的各种细菌,不产氧的光合细菌的种类非常多,主要包括绿硫细菌、绿色非硫细菌、紫细菌等。从《伯杰氏系统细菌学手册》第一版开始就使用不产氧光合细菌(APB)这一名称,以区别光合作用释放氧气的产氧光合细菌—蓝细菌,但国内外一些学者仍习惯沿用“光合细菌”来指代不产氧光合细菌,导致许多不产氧光合细菌的命名和种属归类等方面有些混乱。
在进化关系上,不产氧光合细菌是最早具备光合作用能力的生物,以后才出现了蓝细菌和绿色植物。在绿色植物中,供氧体的化合物为H2O,则有O2产生。光合细菌不能利用H2O,故无O2产生,它们的供氧体为多种无机或有机化合物,例如H2S、硫代硫酸钠、H2、有机酸、醇、甲烷等。不产氧光合细菌能利用大部分有机酸类和醇类等有机物作为供氢体和碳源。此外光合细菌几乎都能固氮,因此在废水处理方面的应用,生物产氢,生物制药,水产与禽畜养殖,提取类胡萝卜素、辅酶Q以及单细胞蛋白等生产实践中应用非常广泛。
参考文献:
1.杨素萍,林志华,崔小华,等.不产氧光合细菌的分类学进展[J].微生物学报,2008,48(11):1562-1566.
11.叶绿体是怎么“复制”的?
细胞中的叶绿体不能从头合成,只能通过分裂或由其他质体分化而来。叶绿体为内共生起源,它的分裂与其祖先蓝细菌在分裂机制上有一定的相似性,但又有宿主真核起源的蛋白参与这一过程。利用电镜观察发现叶绿体分裂时具有中央缢缩现象,随后又证实了在中部的分裂位点存在多个蛋白质组成的环状结构,从叶绿体内膜到外膜依次为:FtsZ环、内侧PD环、外侧PD环和ARC5环,其统称为叶绿体分裂机器。分裂机器部分来源于自身的原核系统,部分来源于真核宿主。通过分裂机器的这些环状结构的收缩,导致叶绿体在中部缢缩断裂,最后形成2个子叶绿体,这种分裂方式叫作二元分裂。
较低等的单细胞藻类中一般只含有一个叶绿体,因此叶绿体的分裂与细胞分裂必须同步以保证每个子细胞都含有一个叶绿体。而较高等的植物细胞中含有多个叶绿体,叶绿体分裂不仅发生在分裂的细胞中,也发生在已经分化不再分裂的细胞中,并且不同类型的细胞中叶绿体数目是不同的。最近研究还发现一些新的蛋白以及脂和肽聚糖等都参与叶绿体分裂或调控,同时也受到基因转录、激素和渗透压等影响,但叶绿体分裂时的很多调控机制和分裂过程的细节还是未知的。
参考文献:
1.李劲宇,安传敬,刘小敏,等.叶绿体分裂分子机制研究进展[J].植物生理学报,2016,52(11):1733-1744.
12.CO2浓度如何影响C3和C4植物的光合作用?
在生理上,C4植物一般比C3植物具有较强的光合作用,这与C4植物的磷酸烯醇式丙酮酸(PEP)羧化酶活性较强有关。CO2固定是通过核酮糖-1,5-二磷酸(RuBP)羧化酶的作用来实现的。C4途径的CO2固定最初是由PEP羧化酶催化来完成的。RuBP羧化酶和PEP羧化酶都可使CO2固定,但它们对CO2的亲和力的差异却很大。
试验证明,C4植物PEP羧化酶的活性比C3植物的强60倍,因此,C4植物的光合速率比C3植物快许多,尤其是在CO2浓度低的环境下,相差更是悬殊。由于PEP羧化酶对CO2的亲和力大,所以,C4植物能够利用低浓度的CO2,而C3植物不能。由于这个原因,C4植物的CO2补偿点比较低,而C3植物的CO2补偿点比较高。所以,C4植物亦称为低补偿点植物,C3植物亦称为高补偿点植物。在炎热干旱的环境下,叶片关闭气孔以减少水分的丧失,这时叶片中二氧化碳浓度大大下降,C4植物便具有比C3植物更高的对炎热、干旱环境的适应性,并保持着较高的光合作用速率。从效率上分析,C4植物的叶肉细胞将低浓度的二氧化碳“泵入”维管束鞘细胞,使维管束鞘细胞的二氧化碳浓度增高到足以被RuBP羧化酶所结合,完成Calvin循环的过程,同时增加了糖的产量,而C3植物就没有这种本领。所以,在干旱环境中,C4植物的生长比C3植物好。
参考文献:
1.潘瑞炽.植物生理学(4版)[M].北京,高等教育出版社
13.光合作用的直接产物只有糖类吗?
光合作用的主要产物是糖类,其中以蔗糖和淀粉最为普遍。长期以来,糖类被认为是光合作用的唯一产物,而其他物质(如蛋白质、脂肪和有机酸)是植物利用糖类再度合成的。实际上这些物质大部分是再度合成的,但也有一部分是光合作用的直接产物,特别是在藻类和高等植物正在发育的叶片中。利用14CO2供给小球藻,在未产生糖类之前,就发现有放射性的氨基酸(如丙氨酸、甘氨酸等)和有机酸(如丙酮酸、苹果酸)出现。实验证明,光合作用也可以直接形成氨基酸和有机酸。
另外,光合产物与不同发育时期的叶片和光质也有关系。一般成长的叶片中主要是形成糖类,而幼嫩叶片中除糖类外,还形成较多的蛋白质;在红光下,叶片形成较多的糖类(包括三碳糖、蔗糖和淀粉),蛋白质较少;而在蓝紫光下,形成的蛋白质、脂肪和核酸的数量增加。由此可见,蛋白质、脂肪和有机酸也都是光合作用的直接产物。因此,应该改变过去认为糖类是光合作用的唯一直接产物的认识。
参考文献:
1.潘瑞炽.植物生理学(4版)[M].北京,高等教育出版社
14.线粒体与叶绿体是怎样增殖的?
(1)线粒体增殖
电镜观察和放射性标记实验研究结果表明,细胞内线粒体是通过分裂进行增殖的。在细胞发育过程中,膜表面积增加,基质蛋白质增多,线粒体也随之生长,线粒体DNA进行复制,然后线粒体再分裂。电镜观察显示,线粒体的分裂约有以下几种方式:
间壁或隔膜分离:线粒体分裂时,先由内膜向中心内褶,或是线粒体的某一个嵴延伸到对缘的内膜进而形成贯通嵴,把线粒体一分为二,使之成为只有外膜相连的两个独立的细胞器,接着线粒体完全分离。这种分裂方式常出现在鼠肝和植物分生组织中。
收缩分离:分裂时线粒体中部缢缩并向两端拉长,整个线粒体约呈哑铃形,最后分开成为两个线粒体。这种分裂方式常见于蕨类和酵母中。
出芽:一般是线粒体上出现球形小芽,然后球形小芽与母体分离,不断长大进而形成新的线粒体。这种分裂方式见于酵母和藓类植物中。
线粒体膜中的脂质被同位素标记,然后再将其转移到没有同位素标记的培养基中,结果发现在之后生长的几代线粒体中都有放射性标记。因此证实了线粒体确实是从原先存在于细胞内的线粒体分裂而来,这一结果与电镜下直接观察到的现象相符。
(2)叶绿体增殖
在个体发育中,叶绿体由原质体分化而来,并通过分裂增殖。通常是叶绿体的近中部处向内收缩,最后分开形成两个子叶绿体。叶绿体数目的增多主要是靠幼龄的叶绿体分裂。成熟的叶绿体通常不再分裂,前质体也不能分裂。叶绿体的分裂一般不需要光,但光对叶绿体的发育是重要的。
线粒体和叶绿体能以分裂的方式进行繁殖,这与细菌的繁殖方式类似。
参考文献:
1.王金发.细胞生物学[M].北京:科学出版社
15.叶绿体内的蛋白质都是叶绿体自己产生的吗?
不是。叶绿体是半自主的细胞器,其基因组也叫叶绿体DNA,双链环状,每个叶绿体中约含12个cpDNA分子。叶绿体具有独立基因组,被认为是内共生起源的细胞器。叶绿体基因组中的基因数目多于线粒体基因组中的,能够编码蛋白质合成所需的各种tRNA和rRNA以及大约50种蛋白质,其中包括RNA聚合酶、核糖体蛋白质、1,5-二磷酸核酮糖羟化酶(RuBP酶)的大亚基等。叶绿体基因组同线粒体基因组一样,都是细胞里相对独立的一个遗传系统。叶绿体基因组可以自主地进行复制,但同时需要细胞核遗传系统提供遗传信息。例如,光合系统Ⅱ中的chla/b蛋白质是在细胞质内的80S核糖体上合成后再转运进叶绿体的;RuBP酶的大亚基是在叶绿体内合成的,但其小亚基则是在细胞质中80S核糖体上合成后转运进叶绿体,然后同大亚基装配成有生物学活性的核糖体。
参考文献:
1.王镜岩.生物化学(下册)[M].北京:高等教育出版社
16.18O标记水分子鉴定0元素的来源去路时,是利用放射性同位素吗?
不是,是利用18O和16O的质量不同进行鉴定的,18O是16O的同位素,但不具备放射性。
元素的原子由原子核和电子构成,而原子核又由质子和中子组成。同种元素具有相同的质子数,但可以有不同的中子数,这种具有相同的质子数而具有不同的中子数的核素互为同位素。其中有一些同位素的原子核能自发地发射出粒子或射线,释放出一定的能量,同时质子数或中子数发生变化,从而转变成另一种元素的原子核。元素的这种特性叫放射性,这样的过程叫放射性衰变,这些元素叫放射性元素,具有放射性的同位素叫放射性同位素。但并不是所有的同位素都有放射性。
同位素标记技术在生产、医疗、农业等领域都有广泛的应用。生物实验中常用到同位素标记法,使用的同位素有两种:(1)放射性同位素如3H、14C、32P、35S、131I、42K等,课本中追踪分泌蛋白合成及分泌的路径就是用3H,鉴定DNA是主要遗传物质就是用32P、35S进行标记的,这些都是放射性标记。(2)稳定同位素(不含放射性)如15N、18O等,例如18O标记水分子鉴定O元素的来源去路,以及用14N和15N验证DNA半保留复制的机制,利用了同位素,但不是利用同位素的放射性,因为它们没有放射性,不要以为“同位素标记法”中使用的都是放射性同位素。
参考文献:
1.王镜岩.生物化学(下册)[M].北京:高等教育出版社
17.色素提取和分离中,层析液改变成分,是否滤纸上色素条带顺序会发生改变?
一般不会改变。层析液是一种脂溶性很强的有机溶剂。叶绿体中的色素在层析液中的溶解度不同:溶解度高的随层析液在滤纸上扩散得快;溶解度低的随层析液在滤纸上扩散得慢。根据这个原理就可以将叶绿体中不同的色素分离开来,四种光合色素在层析液中溶解度从大到小依次是:胡萝卜素、叶黄素、叶绿素a、叶绿素b,所以胡萝卜素随着层析液扩散得最快,而叶绿素b随着层析液扩散得最慢。
课本中提取液一般用丙酮或无水乙醇,层析液是由20份石油醚、2份丙酮和1份苯混合而成的。因此,层析液的配比不同,分离速度和效率也应该略有差别。但根据许多人的实验结果,一般层析液改变只会影响分离速度和分离效率,不会影响各个色素的条带顺序,当然,这只是在做了有限实验的基础上得出的结论,由于无法穷尽所有的层析液,所以结论需要谨慎得出。
参考文献:
1.吕烨,王靖,肖梓雄,等.光合植物叶绿素的提取以及不同植物体内叶绿素含量的探究[J].教育与装备研究,2017(10):39-41.
18.叶绿体能利用细胞呼吸产生的ATP吗?
可以。通常认为光合作用CO2固定所需的ATP来自于由类囊体膜两侧pH梯度驱动的ATP合成过程,然而,一些证据表明,从细胞溶胶中吸收ATP可补充叶绿体的合成代谢,这至少在某些条件下或者某些类型的叶绿体中是如此。当光合作用不能为CO2固定或其他合成代谢提供足量的ATP时,叶绿体就需要吸收ATP。质体的ATP/ADP转运体负责将线粒体产生的ATP从细胞溶胶转运到质体基质中。ATP运输可能对光合ATP/ADP转运体负责将线粒体产生的ATP从细胞溶胶转运到质体基质中。ATP运输可能对光合作用的碳固定产生很少的或实质性的促进作用,程度视ATP的吸收速度而定。在实验中,在光下给甜辣椒的离体叶绿体加入ATP后,淀粉的表观合成速率达到最大值。总之,光反应产生的ATP确实仅用于叶绿体自身的合成代谢,但叶绿体完全可以从细胞溶胶中吸收少部分来自细胞呼吸的ATP,以满足特定条件下叶绿体中的代谢需求,如碳反应、DNA的复制、蛋白质的合成等,实现这一点的分子基础就是位于叶绿体内膜上的ATP/ADP交换转运体。
参考文献:
1.夏献平.中学生物教学热点互动[M].北京:人民教育出版社
19.水的光解需要酶么?
(1)根据潘瑞炽的《植物生理学》第66页,光合作用过程分为三个步骤:
①原初反应(光能的吸收、传递和转换过程);
②电子传递和光合磷酸化(电能转化为活跃化学能过程);
③碳同化(活跃化学能转变为稳定的化学能过程)。
第①②步骤属于光反应,第③步骤属于暗反应。
而水的光解属于第二步骤:电子传递过程。在该过程中,0EC(由多肽即33×103、23×103、18×103及与放氧有关的锰复合物、钙和氯离子组成)被称为放氧复合体,一般认为这是水裂解酶。
(2)人教版教参《生物必修1分子与细胞》教师用书(第2版2012年第15次印刷)中在第111页图19也有关于分解水的酶的相关内容。
(3)在科学出版社出版的丁小燕、陈跃磊等译的《细胞生物学精要》(原著第三版)第477页中,提到水的裂解酶相关知识。
(4)根据《化学通报》2016年第79卷第7期第579页邱兵、景园园、杨新征所著《天然光合放氧反应的理论研究进展》一文中关于Kok循环及转变过程,介绍相关水光解催化过程。
综上:水的光解需要一种被称为放氧复合体(OEC)的水裂解酶参与。
参考文献:
1.潘瑞炽.植物生理学(4版)[M].北京,高等教育出版社
20.叶绿体中光反应的ATP是否只能用于暗反应?还可以用于其他生命活动吗?
(1)ATP和NADPH只能暂时存在但不能累积,是光反应中最早的相对稳定的产物。
ATP和NADPH是光合作用中重要的中间产物,一方面这两者都能暂时将能量贮藏,NADPH的H+又能进一步还原CO2,并形成中间产物。这样,就把光反应和碳反应联系起来。
卡尔文循环大致可分3个阶段,即羧化阶段、还原阶段和更新阶段。还原阶段分两步反应:第一步反应是3-磷酸甘油酸被ATP磷酸化,在3-磷酸甘油酸激酶催化下,形成1,3-二磷酸甘油酸;第二步反应是DPGA在3-磷酸甘油醛脱氢酶作用下被NADPH中的H+还原,形成3-磷酸甘油醛,这就为CO2还原阶段。从3-磷酸甘油酸到3-磷酸甘油醛过程中,由光合作用生成的ATP和NADPH均被利用掉。
(2)最新的研究表明,在某些条件下或者某些类型的叶绿体可以从细胞溶胶中吸收ATP来补充其合成代谢。例如,当光合作用不能为CO2固定或其他合成代谢提供足量的ATP时,叶绿体就需要吸收ATP。叶绿体的ATP/ADP转运体负责将线粒体产生的ATP从细胞溶胶转运到叶绿体基质中。此外实验证据表明,光合作用中CO2固定较多时,光反应产生的ATP主要被叶绿体利用,线粒体为细胞质提供大部分ATP,相反,在CO2固定受限的胁迫条件下,ATP将在叶绿体中积累,然后ATP可以通过代谢物穿梭机制将其输出到细胞溶质中。
此外实验证据表明,光合作用中CO2固定较多时,光反应产生的ATP主要被叶绿体利用,线粒体为细胞质提供大部分ATP,相反,在CO2固定受限的胁迫条件下,ATP将在叶绿体中积累,然后ATP可以通过代谢物穿梭机制将其输出到细胞溶质中。
参考文献:
1.翟中和,王喜忠,丁明孝.细胞生物学[M].北京:高等教育出版社,2011:104.
2.潘瑞炽主编,潘瑞炽,王小菁,李娘辉。植物生理学[M].北京:高等教育出版社,2012:92-93.
来源:生物铭师堂